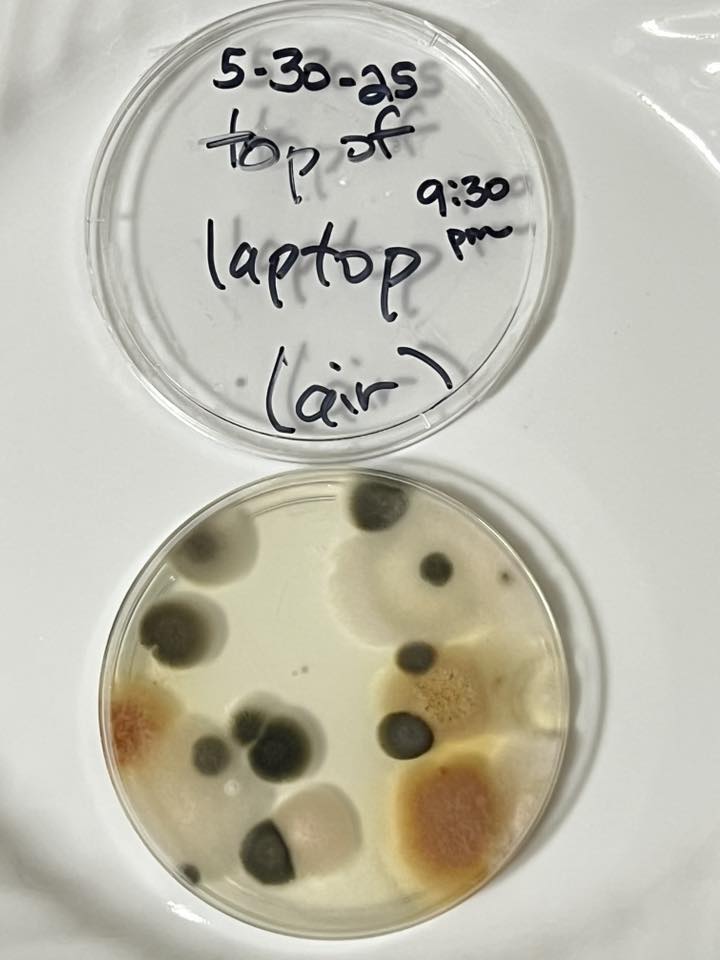
this image shows mold types
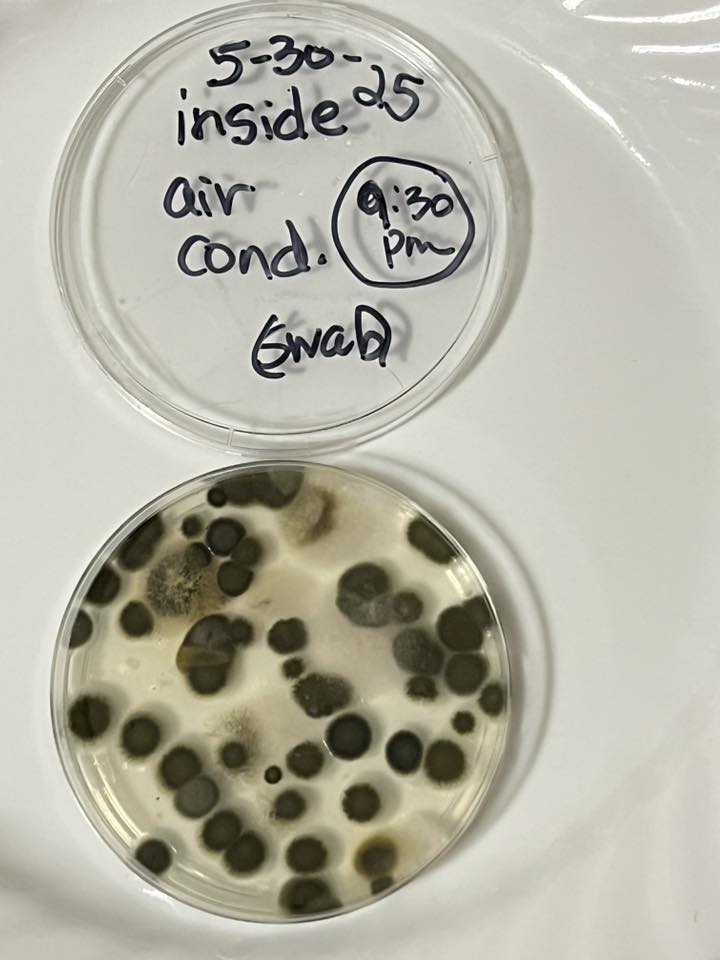
Why Mold Keeps Coming Back

Bathrooms in Florida face a perfect storm for mold growth. High humidity, poor ventilation, frequent water exposure, and warm temperatures create an ideal environment. Showers and baths produce steam, raising humidity levels. Without proper airflow, moisture clings to walls, tiles, and grout.
Florida’s tropical climate worsens this, with year-round humidity often exceeding 60%. The EPA notes that damp, warm spaces are mold magnets. Organic materials like soap scum and drywall provide food for mold spores. In Florida, these conditions make bathrooms a prime target for persistent mold issues compared to drier regions.
Common Types of Mold Found in Bathrooms
Not all mold is the same. Florida bathrooms commonly host four mold types, each with unique traits and risks.
Spotting these molds early helps you act fast. Look for discoloration or fuzzy patches on tiles, walls, or ceilings. The CDC emphasizes identifying mold types for effective removal.

Signs That Indicate the Presence of Mold?
Mold in your bathroom leaves clear clues. A musty, earthy odor signals hidden growth. Visible mold shows as black, green, or white spots on grout, walls, or ceilings. Discoloration, like yellowing tiles, hints at moisture damage. Peeling paint or bubbling wallpaper screams trapped dampness.
Health symptoms, such as sneezing, coughing, or itchy skin, often link to mold exposure. Damp spots or water stains suggest leaks. Warped drywall or soft wood points to structural issues.
How to Inspect for Mold in Your Bathroom?
Checking your bathroom for mold is simple but thorough. Start with a visual inspection. Examine corners, grout lines, under sinks, and behind fixtures for spots or stains. Mold hides in sneaky spots like behind tiles, in ventilation ducts, or under flooring. Use a flashlight to light up dark areas.
A moisture meter, available at hardware stores, detects dampness in walls. Persistent musty smells or health issues, like allergies, suggest mold even if you can’t see it. The EPA recommends regular checks in humid climates like Florida. Catching mold early prevents costly damage and health risks.
Effective Strategies to Prevent Mold Growth in Bathrooms
Stopping mold starts with smart prevention. Run exhaust fans during and after showers for 20-30 minutes to boost ventilation. Open windows to let fresh air flow. Install a dehumidifier to keep humidity below 60%. Fix leaks from pipes or faucets immediately to cut off moisture sources. Choose mold-resistant drywall, paints, or tiles for renovations.
Wipe down walls and fixtures after use to remove water droplets. The FEMA highlights mold-resistant materials as key in humid areas like Florida. These steps create a bathroom that mold struggles to invade.
Maintenance Tips for a Mold-Free Bathroom
Keep your bathroom mold-free with regular upkeep. Inspect for leaks or dampness monthly, focusing on pipes and faucets. Clean tiles and grout with vinegar or mold-inhibiting sprays weekly. Clear drains to prevent water pooling. In Florida’s humid climate, check ventilation systems before summer rains hit.
Use a squeegee to dry shower walls daily. The Florida Department of Health stresses routine maintenance to curb mold. These habits save time and money by stopping mold before it starts.
Why Mold Keeps Coming Back?
Mold returns when moisture lingers. Leaky pipes or poor ventilation create damp havens. Inadequate cleaning leaves spores behind, ready to regrow. Florida’s humidity fuels this cycle. Dry affected areas thoroughly after cleaning.
Assess hidden moisture with professional tools like infrared cameras. Improve airflow with fans or dehumidifiers for lasting results. The EPA warns that unaddressed moisture guarantees mold’s return. Tackle the root cause to break the cycle.
Health Impacts of Bathroom Mold
Mold in bathrooms can harm your health. It triggers allergies, causing sneezing and itchy eyes. Asthma sufferers may face worse symptoms, like wheezing. Respiratory issues, such as coughing, affect many. Skin irritation, like rashes, is common.
Children, elderly, and those with weak immune systems face higher risks. Seek a doctor if symptoms persist. The CDC links mold to serious health concerns. Act fast to remove mold and protect your family’s well-being.

When to Call a Mold Professional?
Call experts for serious mold problems. Extensive growth over 10 square feet needs pro handling. Health concerns, like persistent allergies, demand intervention. Structural damage, such as soft drywall, requires skilled repair. Recurring mold signals hidden issues. DIY removal risks spreading spores or missing roots. Professionals use advanced tools to ensure thorough cleanup.
What to Look for in a Service Provider?
Choose a mold service wisely. Verify certifications like IICRC or NORMI for industry standards. Look for experience in Florida’s humid climate. Read customer reviews on platforms like Yelp for reliability. Ensure they offer inspection, testing, and remediation services. Demand clear pricing with no hidden fees. The Florida Department of Business and Professional Regulation lets you check licenses. A trusted provider delivers peace of mind and lasting results.
Why Choose a Florida-Based Service?
Florida-based mold services excel locally. They understand the state’s humid climate challenges. Experts know Florida building codes and regulations. Local teams respond quickly, minimizing damage. Companies like Miami Mold Specialists tailor solutions to South Florida’s needs. The Florida Department of Health endorses local expertise for effective mold control. Choose nearby pros for faster, smarter service.
FAQ
Why does the mold in my bathroom keep coming back?
Mold returns in bathrooms because moisture persists. leaky pipes, or poor ventilation create damp conditions. Inadequate cleaning leaves spores behind, ready to regrow. Fix leaks, run exhaust fans for 30 minutes after showers, and use a dehumidifier to keep humidity below 60%. Follow these steps and you can control mold from returning in your bathrooms.
Is mold in the bathroom harmful?
Yes, bathroom mold can harm health. It triggers allergies, asthma, and respiratory issues. Some molds, like black mold, are toxic and cause severe symptoms. The CDC warns mold exposure can worsen existing conditions. Remove mold quickly to protect your family.
Can mold in the bathroom cause structural damage?
Mold can weaken your home. It eats away at drywall, wood, and tiles, causing warping or softening. Prolonged exposure leads to costly repairs. Leaks or dampness fuel this damage.
Is it safe to remove mold myself?
Small mold patches—less than 10 square feet—can typically be cleaned safely on your own. Use natural cleaners like vinegar or hydrogen peroxide, wear protective gloves, and ensure the area is well-ventilated.
However, larger infestations or hidden mold pose a greater risk of spreading harmful spores. Improper removal can make the problem worse, so it’s best to contact a professional for extensive or hard-to-reach mold growth.
What are the health risks of bathroom mold?
Mold exposure causes health issues. Allergies lead to sneezing and itchy eyes. Asthma flares up, causing wheezing. Respiratory problems include coughing or shortness of breath. Skin rashes irritate sensitive individuals. The CDC highlights risks for children and immunocompromised people. Address mold to avoid these dangers.
Can mold spread to other parts of the house?
Yes, mold spores travel easily. Air currents or contact with contaminated items spread them. Poor containment during cleaning worsens this. Hidden mold in walls or ducts can invade other rooms. Act fast to stop mold from spreading.
How do I remove mold from tiles and grout?
Clean tiles and grout with vinegar. Spray undiluted vinegar on moldy areas, let it sit for 30 minutes, then scrub with a brush. For tough stains, use hydrogen peroxide.
Conclusion
Mold in Florida bathrooms is more than just an eyesore—it’s a serious health and structural concern. From spotting early warning signs to understanding the types of mold that thrive in humid environments, being informed empowers you to take effective action.
Regular maintenance, proper ventilation, and prompt repairs go a long way in preventing mold from taking hold. While small patches can be handled safely at home, larger or recurring problems require professional expertise. By staying proactive and seeking help when needed, you can protect your home and your health from the damaging effects of mold.






